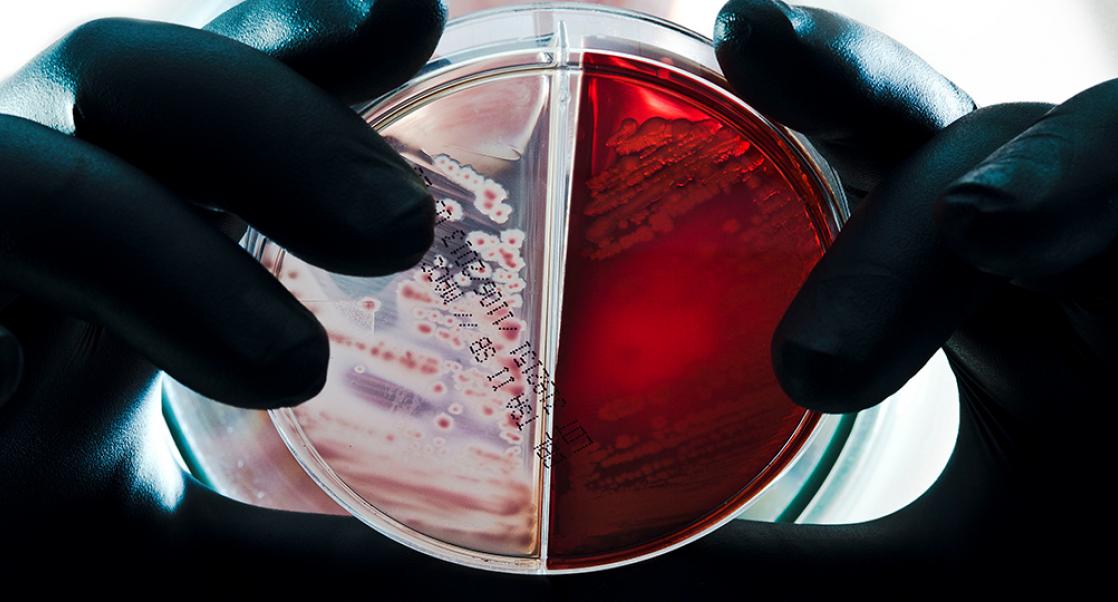
The PharmaLab Congress

Microbial Solutions
|
Eureka Staff
The Key to Environmental Monitoring
From Dublin to Delaware, two experts in microbial detection offer guidance on how companies can ensure their EM programs are working efficiently
For pharmaceutical companies and medical device manufacturers, consistent environmental monitoring is vital to their reputation and bottom line. Pathogens are free-rangers that continually seek places to cohabitate. When unwanted pathogens go unnoticed it can slow down manufacturing cycles and damage a company’s reputation by forcing recalls.
Companies naturally want to ensure this doesn’t happen, but doing the due diligence isn’t easy. It requires fast tools capable of discerning not just the usual suspects but brand new ones that we don’t know much about. Many companies don’t have the skilled personnel, laboratories, and equipment to meet these goals, but there are contract laboratories that can provide such expertise, using tools that can deliver results faster than ever before. Eureka recently asked two resident experts from our Microbial Solutions business, Gilles Goy and Beth Burke to participate in a brief Q&A. Here are their edited responses.
Companies naturally want to ensure their sites are free of dangerous pathogens. Are they getting faster at tracking them?
GG: It depends. The amount of time it takes to identify microorganisms using the current methods is driven by the technology being used. The best technologies allow a company to respond rapidly faster to incidents where contamination has occurred. As they saying goes, time equals money; a delayed investigation can mean lost revenues and a damaged reputation. By relying on laboratories that specialize in state-of-the-art microbial identification, companies can get accurate results in real-time almost 100% of the time.
BB: This really depends on criticality of the sample. Most companies set alert and action limits based on risk and criticality of their sampling area. We find that our customers make decisions as to the choice of technology and turn-around-time to result based on this criteria. Tracking and trending these results in real-time is extremely important. It not only allows them to respond swiftly in the case of a critical investigation, but also allows for monitoring to prevent such events and keep their process in a state of control.
What are the common difficulties manufacturers face when they try to streamline their EM monitoring programs?
GG: Quite simply, they don’t usually have the in-house expertise to do this. Tracking microbes is not the typical skill set of a medical device manufacturer or a pharmaceutical company. A comprehensive Environmental Monitoring program is a complex job and it’s difficult for a manufacturer to find highly skilled technicians able to do it. One way to overcome this is by partnering with a laboratory that specializes in microbial identification. In these situations, the microbial laboratory is more than a contractor, they become part of the same team with the shared goal of helping to keep a client’s facility free of unwanted pathogens.
BB: In addition, these customers may not have access to the most up-to-date technologies and libraries for accurately identifying their microorganisms. Investing in equipment, validation and training analysts can be quite costly and can often many months, or even years, to accomplish. I should add that accurate identification is all about the library. You need access relevant comprehensive and up-to-date databases for environmental isolates to be able to identify pathogens that might find their way into a manufacturing floor or pharmaceutical space.
What tracking and trending tools and features do you think would help contribute the most to a successful program?
GG: Data Integrity is the word of the day! Paperless barcode-based systems allow labs to execute all their operations in compliance with data integrity requirements. At my company, for instance, any operation, reagent, accessory or skill is tracked in our Laboratory Information Management System, thanks to a fancy Smart Barcoding tool. Any expiration date, validation due date or even lab tech qualification is then detected by the system.
BB: The validated barcoding system Gilles mentions above is also critical in ensuring sample integrity throughout complex lab processes in high-volume labs such as ours. It mitigates any possibility of sample mix ups or other issues inherent with manual processes. Data integrity requirements also show the relevance of tracking and trending identification results. We offer a free tracking and trending data management software that generates sophisticated reports that can help to drive decisions, address issues, prove compliance, and maintain knowledge and control of the overall environmental monitoring program.
What makes a relevant library when it comes to the pharma industry?
GG: Two words: Suitable and Representative. A suitable library contains microorganisms industries typically detect in their environment. A representative library contains enough entries to get a reliable and accurate identification.
BB: Having the most accurate identifications means that libraries need to be maintained and validated to stay current with an evolving microbial world, where taxonomic changes and new species are described daily. To ensure that we continually provide the best identification services available, we need to routinely evaluate our identification rate, monitor lists of frequently occurring organisms and manage newly described organisms relevant to our industry with an extensive testing and review prior to approval and entry. Relevance our industry is extremely critical as many off-the -shelf identification systems are geared to clinical applications.
Gilles Goy is a Senior Lab Manager of the Microbial Solutions site based in Dublin. Beth Burke is Director of Operations with the Accugenix unit based in Delaware. You can find more information on Charles River’s Dublin site here. You can find information about Accugenix libraries and reporting here.